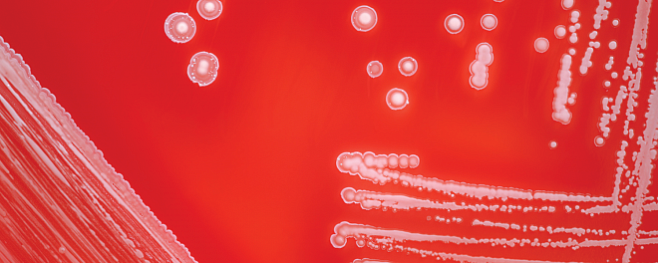
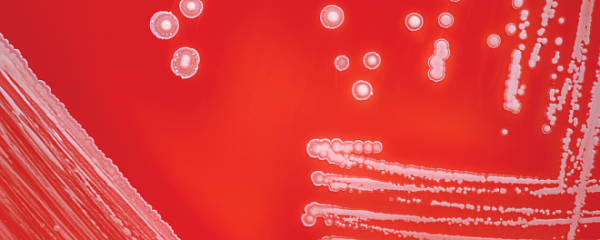

Хронические раневые инфекции связали с микробным разнообразием и генетикой

Генетик Калеб Филлипс из Техасского технологического университета и его коллеги проанализировали образцы ДНК 85 пациентов Юго-Западного регионального центра лечения ран на разнообразие бактерий в их инфицированных ранах.
Им удалось выяснить, что у пациентов с однонуклеотидным полиморфизмом в гене TLN2, отвечающем за сборку актина (белка мышечных волокон), и гене ZNF521, кодирующем фактор транскрипции, общее микробное разнообразие в ранах было ниже, а сами они чаще заражались синегнойной палочкой и стафилококком.
Также кожные раны таких пациентов дольше заживали, что позволило авторам исследования предположить, что именно мутации в генах TLN2 и ZNF521 ответственны за больший риск развития хронических раневых инфекций, а однонуклеотидный полиморфизм может служить биомаркером для определения таких пациентов.
Фото: ISTOCK.COM, KSASS
Наука
Екатерина Луконина


 Загадочные новогвинейские поющие собаки снова найдены в дикой природе
Загадочные новогвинейские поющие собаки снова найдены в дикой природе В США начались клинические испытания на людях вакцины от коронавируса
В США начались клинические испытания на людях вакцины от коронавируса








